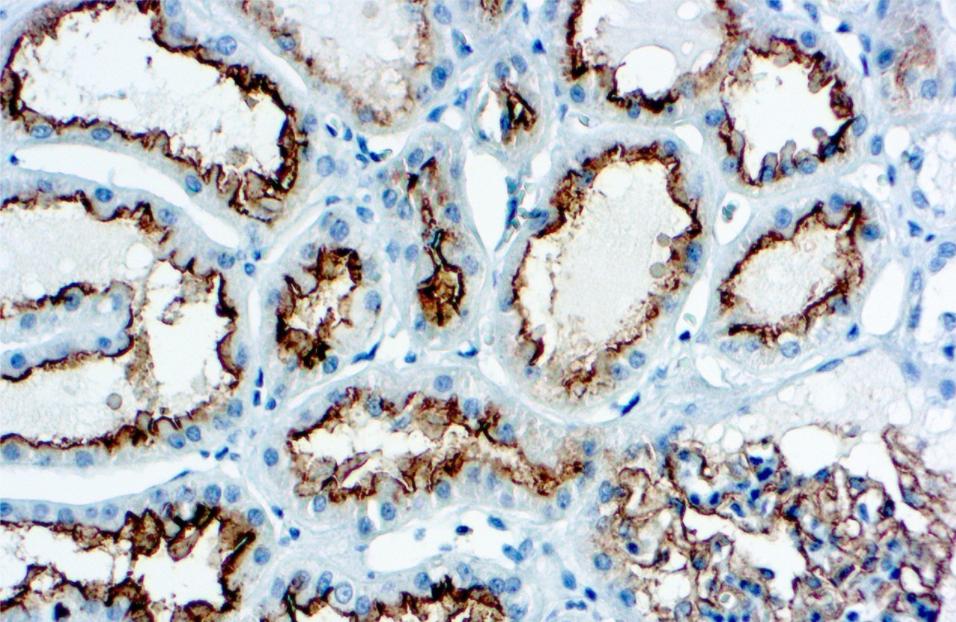
这七个体检指标异常不用过度治疗,14项体检常见指标异常解读

随着经济的发展,人们对生活质量的要求越来越高,对身体的健康要求也越来越严格,所以体检已经逐渐成为我们生活中的一部分,因为体检报告在一定程度上反映了我们的身体状况。
从预防医学上来讲,所有人每年至少要定期参加一次体检,超过35岁的人群必须每年进行一次体检。许多疾病在前期或是中期,身体出现的不适症状不明显,然而,一旦疾病进入后期,身体出现严重的病症,可能就为时已晚。
所以,体检对疾病的预防至关重要,体检能够及时发现病情,尽早治疗。
体检是一个初步的筛查结果,准确度并不是100%,无法检测出所有疾病。然而有许多并不正规医疗卫生机构,开展检验儿童体内含有的微量元素含量,那么体检真的能检测出体内的微量元素吗?

一、体检能够查出微量元素,是真的吗?
现代医学发展越来越专业,愿意在医疗方面花费的人越来越多,也给那些黑心商家带来了可乘之机,许多医学机构声称自己能够检测出孩子体内所含有的微量元素。
但早在2013年10月原国家卫计委就发布了关于规范儿童微量元素临床检测的通知,明确指出“不可将微量元素检测作为体检项目,尤其是在未满一岁的婴儿身上”。
微量元素由60多种元素组成,凡是占人体总重量的万分之一以下的元素,比如说铁、锌、铜,锰等,都被称之为微量元素。
微量元素在人体内的含量微乎其微,虽然含量较少,但是对人体健康起着重要作用,微量元素自身无法合成,必须从食物中补充,微量元素摄入过多或过少都会引起身体的不适,从而引起疾病。

所以,许多家长担心孩子缺少某类微量元素影响生长,于是便带孩子前往那些宣传能够进行微量元素检测的体检机构进行检查,但国家早已明令禁止。
据医学专家所说,国内外关于体内微量元素的检测至今都没有一个公认的准确方法,我国著名医学专家杨晓光曾说“通过检测静脉血的血清或血浆中的微量元素含量,可以了解一个大概情况,但这并不一定准确,还需要通过临床医学症状来综合判断”。
每个人的体内都含有许多不同种类的微量元素,每个微量元素营养状态的指标不同,比如铁含量的判定方法是骨髓染色法,但这在目前的医学上很难做到。

目前最常用于检测铁含量的检测指标是血红蛋白,但影响血红蛋白的因素有很多,并不能做出准确的结果。
由于微量元素在体内所占比例较小,受影响因素较多,想要获得准确的结果非常困难, 除了人体必须微量元素外,对于癌症的预防,人们也是十分关注,那么体检能够检测出癌症吗?
二、体检发现肿瘤标志物升高,是患有癌症了吗?
以前人们一听到癌症便会觉得无药可医,但随着时代的发展,医疗设备与医疗技术的完善,人们对癌症的预防也变得越来越全面,定期体检变成了预防癌症的一个好的选择。
因为现如今,人们对健康的要求日益增加,导致体检的项目逐年增多,体检中“肿瘤标志物筛查”成了不少人追捧的健康体检项目。
有人说肿瘤标志物数据升高就是患有癌症,那么这个说法是真的吗?有专家对此进行了解释。

肿瘤标志物升高,不代表100%是癌症,肿瘤标志物结果一般不可能为零。因为每个人的体内都含有癌细胞,在新细胞生成的同时,也会有突变的细胞生成,只是在身体免疫力正常的情况下,癌细胞会被机体的淋巴细胞识别并消灭。
所以肿瘤标志物数据往往会有一个正常范围,只要数值在正常范围内就是正常的。
虽然说“肿瘤标志物”大多数存在于恶性肿瘤中,但是肿瘤标志物的影响因素较多,饮酒、服用药物或是身体其他疾病(妊娠状态,肝炎病人等)都会引起肿瘤标志物数据波动。所以,并不能肿瘤标志物升高并不代表癌症的出现。
但需要注意的是,即使没有癌症,但肿瘤标志物出现异常,也可能是说明身体其他地方出现了异常。可见,肿瘤标志物数据并不是没有作用,其数据可以作为癌症发生的辅助诊断。如果想要确定自己是否患有癌症,还需要结合其他的检查,如CT、B超或是肠镜,胃镜检查。
“肿瘤标志物”比较适合高危人群的预防和筛查,以及已经被确诊为恶性肿瘤的患者。体检能够有效地预防疾病,那么怎样通过体检来判断自己健不健康呢?下面这五个指标正常就可以说明身体健康。
三、中老年人体检时,这五个指标正常,说明身体健康!
现如今人人都想着身体健康,“保温杯里泡枸杞”已经成了现在大众的常态。
中老年人尤其需要,随着年龄的增加,身体状况会变得越来越差,就像一台机器,机器时间越长,越不好用。所以,我们要对身体进行保养。

为了清楚地知道身体状况,要定期进行体检,及时发现身体中潜在的疾病威胁,提前预防,将疾病扼杀在摇篮中。
体检单上的数据可以作为一个身体健康的参照标准,以下五个数据对中老年人来说尤其重要,让我们一起来看看吧。
首先是中老年人最关注的血压问题,中年人正常的血压标准通常是小于140/90mmHg,这个标准是专业诊室血压的标准,一般普通家庭所购买的测血压器的标准往往是小于135/85mmHg,这个是临床医学上的标准,是一个参考范围。在
医学上真正的理想血压应该是小于120/80mmHg,当收缩压波动在80-89mmHg时属于一个正常范围或临界高血压,如果收波高于90mmHg这个时候就需要注意我们的的血压波动情况了。

血脂也是不可避免的问题,血脂是血浆中甘油三酯和类脂的总称,广泛存在与人体内,血脂是生命细胞代谢的基本物质,一般来说,总胆固醇的正常范围是2.8-5.1mmol/L,甘油三酯0.56-1.7mmol/L,男性高密度脂蛋白胆固醇正常范围在0.96-1.15mmol/L,女性的在0.9-1.55mmol/L,这个范围会根据每个医院的规定而产生轻微差别。
评价一个人的血糖是否正常,是以静脉血浆葡萄糖为标准,一般空腹的静脉血浆葡萄糖,正常人的数据小于6.1mmol/L(这里的空腹是空腹时间大于8小时)餐后两小时的静脉血浆葡萄糖。
正常人小于7.8mmol/L,如果空腹血糖大于6.1mmol/L,小于7.0mmol/L就处在糖尿病前期,这个时候我们就要注意自己的血糖问题,需要注意我们日常生活中的饮食。

尿酸也是中老年人体检时的重要项目,尿酸高是痛风的主要原因,中年正常男性的血尿酸往往在150-380之间,女性往往在100-300之间,但是尿酸具有不稳定性,不同检查数据之间的差别会较大,所以需要反复检测。
如果尿酸值持续大于420,就可以确诊为高尿酸血症。大约有5%-15%左右的高尿酸血症很大可能会发展为痛风,还有可能会引发肥胖,高血压,动脉硬化等问题,在饮食上要注意,少吃海鲜,高汤等含嘌呤较高的食物。
肾脏功能与肝功能也是中老年人需要注意的问题,肾脏是控制体内新陈代谢的器官,可以将体内的废料排泄出去,有生成尿液的功能。肝主要是代谢毒素,制造肝糖,两者都对身体起着重要作用。

体检数据这两项良好的话,就可以避免很多疾病。肾不好会导致肾衰竭,严重的可能患有尿毒症,肝不好,可能会造成脂肪肝等疾病,对身体危害重大。
血压,血脂,血糖,尿酸,肝肾功能这五项指标可以大体上反映出一个人的身体状况,中老年朋友格外要注意,每年都要定期进行体检,条件允许的话,可以多做几次体检,以预防疾病的发生。
延伸阅读:七种癌症早期的有效筛查方法,建议收藏!
癌症并不可怕,只有检查方法得当,或在癌症的早期积极治疗,就可以有效地治愈癌症,下面是十种有效的癌症早期筛查方法。
结直肠癌的主要预防方法是做肠镜检查,每五年做一到两次,可以有效预防结直肠癌。

其次是两项针对女性的检查,乳腺癌,乳腺癌是女性最高发的癌症,非常容易在早期检查出来,乳腺鉬靶x光线就可以检查出来,辐射量远小于其他x光片检查,并且有较高的准确性。
宫颈癌可以通过帕氏涂片和HPV病毒检查出来,也是有非常高的准确性,目前也可以接种预防宫颈癌的疫苗,也就是我们常说的九价疫苗,具有很好地预防效果。
肝癌可以通过CT检查、核磁共振以及检测肝脏的肿瘤标志物数据来进行预防,通过这三种手段可以做出正确判断。而经常喝酒的人群比较容易患上肝癌,所以喝酒爱好者要经常检查肝功能以预防肝癌。
胃癌可以通过胃镜检查出来,结合血样定期体检可以有效预防胃癌。饮食作息不规律的人要注意,要经常去做胃镜检查。

肺癌也是我国发生较多的癌症,可以通过低剂量螺旋CT检查出来,其比常规CT对人体的伤害更小。
这七种癌症是较为常见的癌症,预防和对其的治疗技术已经相对成熟。但需要注意的是,有的癌症具有家族遗传的隐患,所以当父母或长辈患有癌症的时候也需要去医院进行检查,以免出现基因遗传的现象,要尽早治疗。
温馨提示
定期体检可以有效检测出疾病,可以将疾病扼杀在摇篮里,所以定期做体检非常重要,各个年龄段都需要重视,以免疾病发生而错过最佳治疗时间,带来更大的身体健康隐患。
青年人可以一年做一次体检,但中老年人就需要一年做两到三次体检,如果对体检单上的数据有疑问,前往医院进行询问,不可将体检视为儿戏。